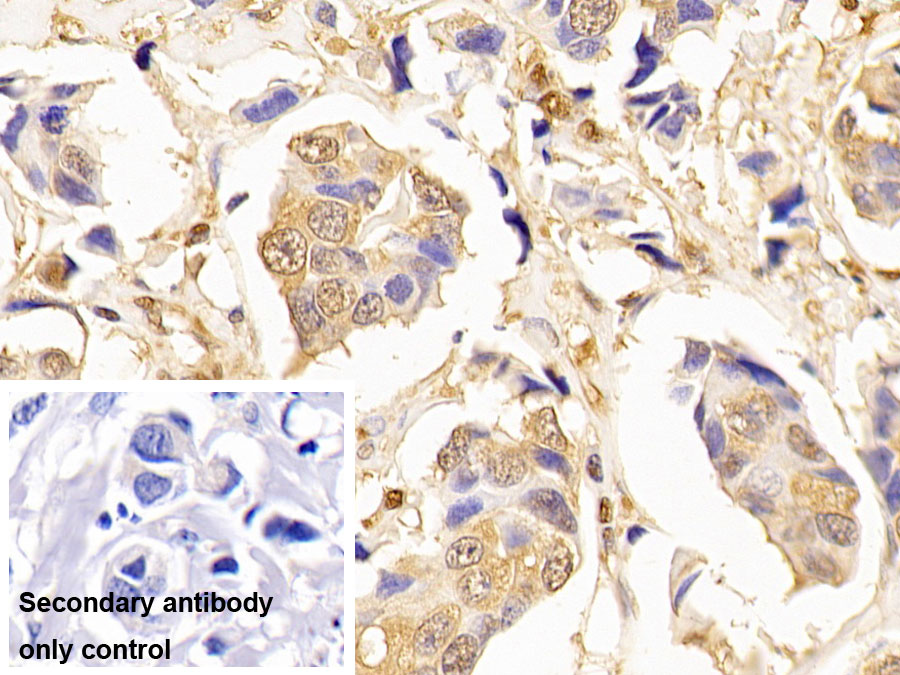

Monoclonal Antibody to Glyceraldehyde-3-Phosphate Dehydrogenase (GAPDH)


Product No.: MAB932Hu25
Organism species: Homo sapiens (Human)

Monoclonal Antibody to Glyceraldehyde-3-Phosphate Dehydrogenase (GAPDH)


Product No.: MAB932Hu27
Organism species: Homo sapiens (Human)

Monoclonal Antibody to Glyceraldehyde-3-Phosphate Dehydrogenase (GAPDH)


Product No.: MAB932Hu29
Organism species: Homo sapiens (Human)
Monoclonal Antibody to Hemojuvelin (HJV)


Product No.: MAB995Hu27
Organism species: Homo sapiens (Human)
Monoclonal Antibody to Hemojuvelin (HJV)


Product No.: MAB995Hu29
Organism species: Homo sapiens (Human)

Monoclonal Antibody to Glyceraldehyde-3-Phosphate Dehydrogenase (GAPDH)


Product No.: MAB932Hu26
Organism species: Homo sapiens (Human)

Monoclonal Antibody to Glyceraldehyde-3-Phosphate Dehydrogenase (GAPDH)


Product No.: MAB932Hu28
Organism species: Homo sapiens (Human)
Monoclonal Antibody to Apolipoprotein B (APOB)


Product No.: MAC003Hu26
Organism species: Homo sapiens (Human)
Monoclonal Antibody to Allopregnanolone (AP)


Product No.: MAB963Ge22
Organism species: Pan-species (General)
Monoclonal Antibody to Allopregnanolone (AP)


Product No.: MAB963Ge24
Organism species: Pan-species (General)
Monoclonal Antibody to Cyanocobalamin (CNCbl)


Product No.: MAA924Ge22
Organism species: Pan-species (General)
Monoclonal Antibody to Apolipoprotein A5 (APOA5)


Product No.: MAB997Po21
Organism species: Sus scrofa; Porcine (Pig)
Monoclonal Antibody to Cyanocobalamin (CNCbl)


Product No.: MAA924Ge23
Organism species: Pan-species (General)
Monoclonal Antibody to Collagen Type IV Alpha 5 (COL4a5)


Product No.: MAC141Hu22
Organism species: Homo sapiens (Human)

Monoclonal Antibody to Collagen Type IV Alpha 3 (COL4a3)

